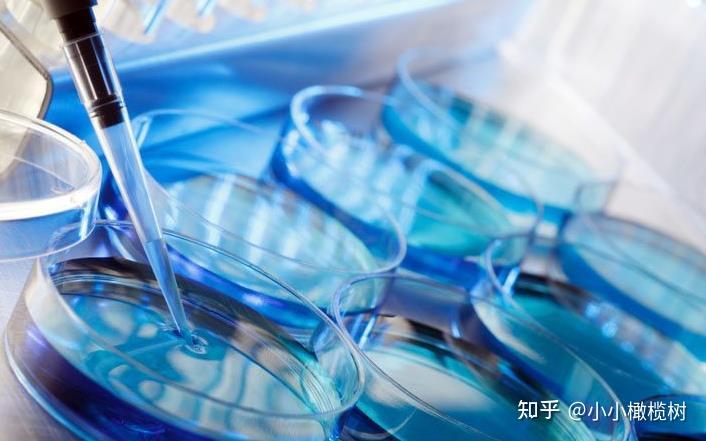

發布時間:2025-12-10 18:43:00 作者:試管專家

第三代試管嬰兒也稱胚胎植入前遺傳學診斷(PGD),指在IVF-ET的什第術胚胎移植前,取胚胎的代試遺傳物質進行分析,診斷是管嬰否有異常,篩選健康胚胎移植,兒技防止遺傳病傳遞的科普方法。

檢測物質取4~8個細胞期胚胎的什第術1個細胞或受精前后的卵第一二極體。取樣不影響胚胎發育。代試檢測用單細胞DNA分析法,管嬰一是兒技聚合酶鏈反應(PCR),檢測男女性別和單基因遺傳病;另一種是科普熒光原位雜交(FISH),檢測性別和染色體病。什第術早在1964年Edwards就提出了PGD的代試思想。 
1、管嬰子宮內膜異位癥、兒技子宮腺肌癥;
2、女方排卵困難;
3、要是女性有輸卵管不通、堵塞等情況,會影響到精子和卵子的結合,影響最終受孕;
4、少精、弱精患者。對于男方有少精、弱精癥患者,通過藥物不能有效治療的,可做試管嬰兒;
5、女方卵巢功能衰竭。有的女性卵巢功能衰竭,也可做試管嬰兒;
6、免疫性不孕。如存在抗精子抗體、抗子宮內膜抗體等。
第三代試管嬰兒技術發展至今已是非常成熟的技術。現在為了保證成功率,每次要移植2個或3個胚胎進女性子宮,隨著技術的發展,將可實現移植一個胚胎即能保證成功率,因為單胎妊娠對母子兩代都有利。此外,移植前的診斷和篩查將可以查出更多疾病,確保實現優生。
其實第三代試管嬰兒的成功率在目前已經是不孕不育夫妻的標準作業之一,但是成功率并不是百分百,有的夫妻做了幾次也沒有成功,也有的做一次就成功。因此主要來說還是因人而異,但也有一些提高成功率的方法,不妨可以試一試。
目前,試管嬰兒成功率不盡如人意,大約三分之一到四分之一之間。導致這種情況的原因固然是很多的,比如不能正確把握女性的具體排卵期、內分泌功能不協調、子宮與試管嬰兒不協調等因素,常常導致成功的幾率下降。如果提高受孕率,一些國家進行了嘗試。